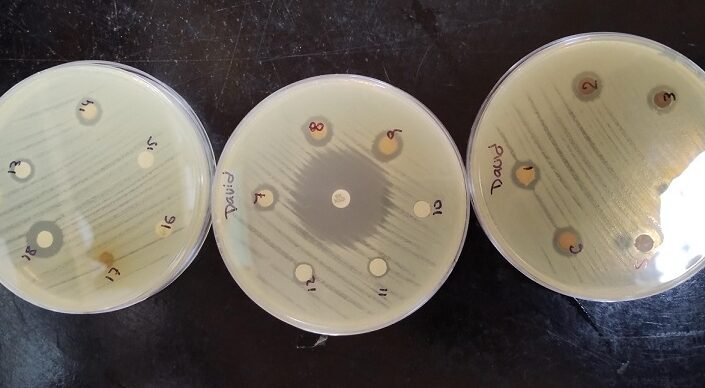
nanoparticulas-de-plata-propiedades-y-riesgos-en-medicina

Las han captado gran interés en la comunidad científica por su potencial terapéutico y antibacteriano. Estas partículas, de tamaño nanométrico, exhiben propiedades únicas como alta conductividad, capacidad antimicrobiana y versatilidad en aplicaciones biomédicas. Sin embargo, su creciente uso también plantea interrogantes sobre posibles riesgos toxicológicos y efectos secundarios en humanos y el medioambiente. Este artículo explora las características fundamentales de las nanopartículas de plata, sus beneficios en tratamientos médicos y los desafíos asociados a su seguridad, con el fin de ofrecer una visión equilibrada entre innovación y precaución.
Nanopartículas de plata: Propiedades y riesgos en medicina
Las nanopartículas de plata han cobrado relevancia en el campo médico debido a sus propiedades antimicrobianas, antiinflamatorias y de cicatrización. Sin embargo, su uso también presenta riesgos potenciales para la salud y el medio ambiente, lo que exige un análisis riguroso de sus aplicaciones y efectos adversos. A continuación, se detallan aspectos clave sobre su uso en medicina.
Propiedades antimicrobianas de las nanopartículas de plata
Las nanopartículas de plata son ampliamente utilizadas por su capacidad para inhibir el crecimiento de bacterias, hongos y virus. Su mecanismo de acción incluye la liberación de iones de plata que dañan las membranas celulares y el ADN de los microorganismos. Esta propiedad las hace útiles en recubrimientos de dispositivos médicos, apósitos para heridas y terapias contra infecciones resistentes.
Aplicaciones médicas actuales
En medicina, las nanopartículas de plata se emplean en dispositivos como catéteres, prótesis y suturas para prevenir infecciones. También se integran en cremas tópicas para el tratamiento de quemaduras y heridas crónicas. Su eficacia en la reducción de la carga bacteriana ha sido respaldada por numerosos estudios clínicos.
Riesgos toxicológicos
El uso de nanopartículas de plata en medicina no está exento de riesgos. Estudios han demostrado que la exposición prolongada puede causar toxicidad celular, daño hepático y renal, e incluso alteraciones genéticas. La acumulación de plata en tejidos representa un desafío para su uso seguro en terapias a largo plazo.
Impacto ambiental
La liberación de nanopartículas de plata en el medio ambiente, especialmente a través de aguas residuales, puede afectar a ecosistemas acuáticos y terrestres. Su persistencia y capacidad para bioacumularse en organismos vivos generan preocupaciones sobre la sostenibilidad de su uso médico.
Regulaciones y normativas
El uso de nanopartículas de plata en medicina está sujeto a regulaciones estrictas en muchos países. Agencias como la FDA y la EMA evalúan su seguridad antes de su aprobación. Sin embargo, la falta de estándares globales uniformes plantea retos para su regulación efectiva.
| Propiedad | Aplicación médica | Riesgo asociado |
| Antimicrobiana | Recubrimiento de catéteres | Toxicidad celular |
| Antiinflamatoria | Tratamiento de heridas | Acumulación en tejidos |
| Conductividad | Biosensores | Contaminación ambiental |
Preguntas Frecuentes
¿Qué son las nanopartículas de plata y cómo se utilizan en medicina?
Las nanopartículas de plata son partículas microscópicas con tamaño entre 1 y 100 nanómetros, conocidas por sus propiedades antimicrobianas y antiinflamatorias. En medicina, se utilizan en aplicaciones como recubrimientos de implantes, vendajes para heridas y agentes terapéuticos para infecciones, gracias a su capacidad para inhibir el crecimiento de bacterias y hongos.
¿Cuáles son los beneficios principales de las nanopartículas de plata en tratamientos médicos?
Los principales beneficios incluyen su alta eficacia contra patógenos resistentes a antibióticos, su capacidad para acelerar la cicatrización de heridas y su versatilidad en formulaciones, como geles o sprays. Además, su tamaño nanométrico mejora la penetración en tejidos, potenciando su acción terapéutica.
¿Existen riesgos asociados al uso de nanopartículas de plata en medicina?
Sí, aunque son prometedoras, las nanopartículas de plata pueden presentar riesgos como toxicidad celular, acumulación en órganos (especialmente hígado y riñones) y posibles efectos citotóxicos en altas concentraciones. También se estudia su impacto ambiental por liberación incontrolada.
¿Cómo se regula el uso de nanopartículas de plata en aplicaciones médicas?
Su regulación varía por país, pero generalmente sigue normas de agencias como la FDA (EE.UU.) o la EMA (UE), que evalúan su seguridad, eficacia y dosificación. Se exigen estudios preclínicos y clínicos para garantizar que sus beneficios superen los posibles riesgos para la salud.

















